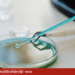
package media 12502733926702112795183 81424765614405286038840.png

Tết là thời điểm sum vầy cũng là lúc bàn ăn luôn đầy ắp những món ngon truyền thống. Tuy nhiên, theo bác sĩ Đoàn Thị Mỹ Hòa, Khoa Dinh dưỡng – Bệnh viện Đa khoa Thủ Đức (TPHCM), nỗi lo lớn nhất của nhiều người trong những ngày Tết không chỉ là tăng cân mà còn là tình trạng đầy bụng, khó tiêu, mệt mỏi và rối loạn đường huyết do ăn uống thiếu kiểm soát.
Bác sĩ cho biết, điều quan trọng không phải là nhịn ăn hay kiêng khem quá mức mà là ăn uống tỉnh thức, hiểu rõ cơ thể cần gì, ăn chậm, ăn đúng và biết dừng lại đúng lúc.

Bác sĩ Hòa chia sẻ 4 nguyên tắc đơn giản nhưng hiệu quả giúp bạn tận hưởng Tết trọn vẹn mà không lo nặng bụng:
Thứ nhất, thay đổi trình tự ăn trong bữa chính
Thay vì ăn cơm, xôi hoặc bánh chưng ngay từ đầu, bạn nên lót dạ bằng một đĩa salad, rau luộc hoặc canh rau trước, sau đó mới đến các món thịt, cá. Chất xơ từ rau xanh sẽ tạo thành một “tấm lưới” trong dạ dày, giúp làm chậm quá trình hấp thu đường, khiến bạn no nhanh hơn và hạn chế tình trạng đường huyết tăng vọt sau ăn – nguyên nhân gây buồn ngủ, mệt mỏi.
Thứ hai, cảnh giác với “calo tàng hình”
Ngày Tết, các loại hạt như hạt điều, hạnh nhân, hướng dương thường được người dân ưa chuộng. Tuy nhiên, đây lại là nhóm thực phẩm rất giàu năng lượng. Bác sĩ khuyên bạn hãy lấy ra một lượng nhỏ, tương đương một nắm tay khép kín, cho ra đĩa riêng và chỉ ăn hết phần đó để tránh vô tình nạp quá nhiều calo.
Thứ ba, ghi nhớ nguyên tắc quy đổi tinh bột
Nhiều người không nhận ra mình đã ăn quá nhiều tinh bột khi vừa ăn bánh chưng vừa ăn cơm lại thêm nước ngọt. Hãy nhớ cách quy đổi: 1 góc bánh chưng = 1 bát xôi = 1 bát cơm tẻ = 1 lon nước ngọt. Nếu trong bữa đã có bánh chưng, bạn nên chủ động giảm hoặc bỏ cơm để tổng lượng tinh bột không vượt ngưỡng.
Thứ tư, duy trì vận động nhẹ nhàng mỗi ngày
Không cần tập luyện nặng trong ngày Tết, bạn chỉ cần duy trì các hoạt động sinh nhiệt không tập luyện như đi bộ chúc Tết, dọn dẹp nhà cửa, lau bàn ghế hay rửa bát cũng giúp tiêu hao năng lượng đáng kể, hỗ trợ tiêu hóa và hạn chế tích mỡ bụng.

Trà xanh được nhiều người ưa chuộng nhờ giúp tỉnh táo, thanh nhiệt và hỗ trợ sức khỏe. Tuy nhiên, không phải ai uống trà cũng tốt.

Không chỉ dễ tìm, dễ ăn, chuối còn được xem là lựa chọn đơn giản nhưng hiệu quả giúp cơ thể phục hồi thể trạng sau rượu bia.

Sở hữu màu đỏ tím đặc trưng cùng giá trị dinh dưỡng cao, củ dền được nhiều người lựa chọn như thực phẩm hỗ trợ giải độc gan, tốt cho tim mạch và tạo máu.